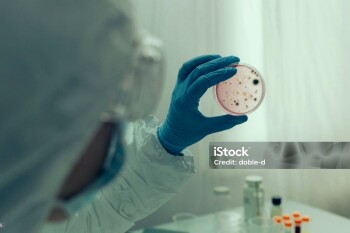

Тег: готовность
2.06.2026, 17:45
В ЗКО прошли республиканские командно-штабные учения «Өрт-2026»4.03.2026, 10:00
Гражданская оборона: готовы к спасению18.11.2025, 14:30
В ЗКО успешно завершились командно-штабные учения «Қыс-2025»8.04.2025, 17:15
Глава ВОЗ призвал готовиться к новой пандемии2.04.2025, 12:45
Сколько казахстанцев призовут на воинские сборы в 2025 году17.03.2025, 9:30
Сельский округ Курмангазы к чрезвычайным ситуациям готов12.03.2025, 17:30
Средний уровень паводка ожидается в ЗКО20.02.2025, 11:15
Водохранилища ЗКО заранее подготовили к приему воды6.02.2025, 16:00
В Аксае проверили готовность к паводку6.02.2025, 9:30
Аким области побывал в Таскалинском районе29.01.2025, 15:45
Аким района Бәйтерек проверил готовность к весеннему паводку